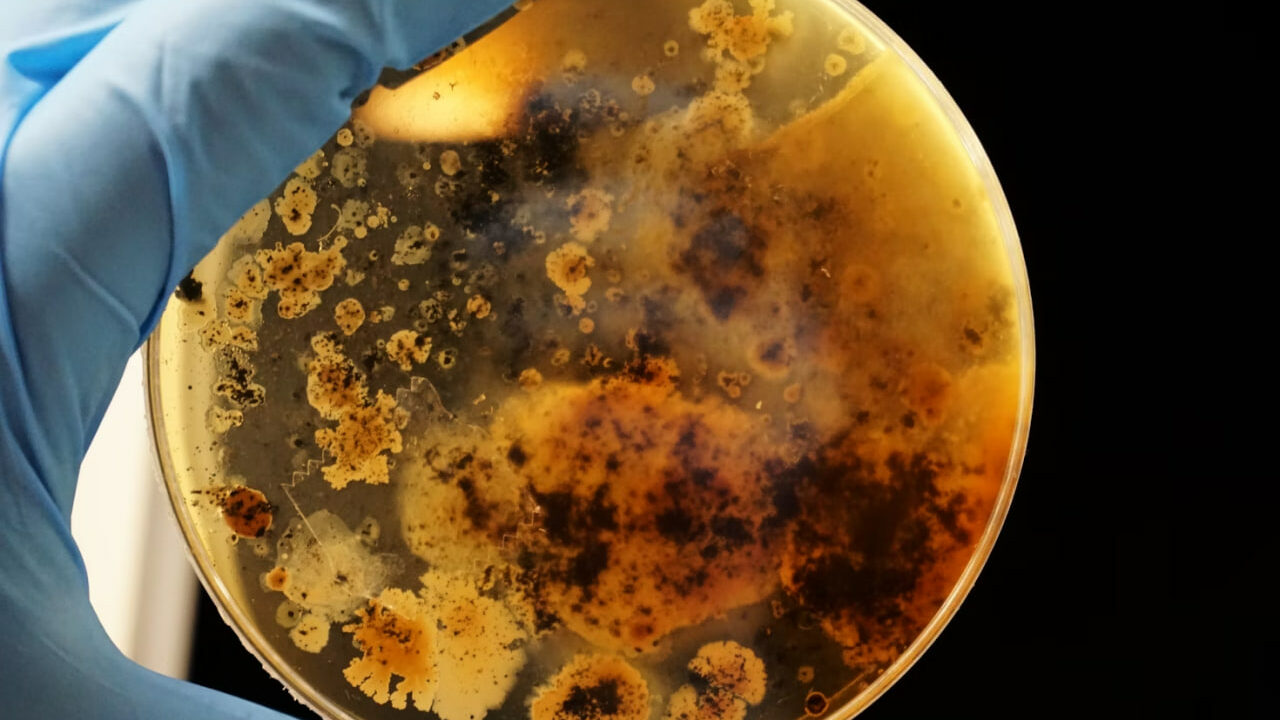
бактерії

кафе
Новости здоровья
14 детей в больнице с острой кишечной инфекцией: в Киеве вспышка из-за посещения кафе

Новости здоровья
Все посещали одно кафе: в Хмельницкой области 11 человек заразились кишечной инфекцией